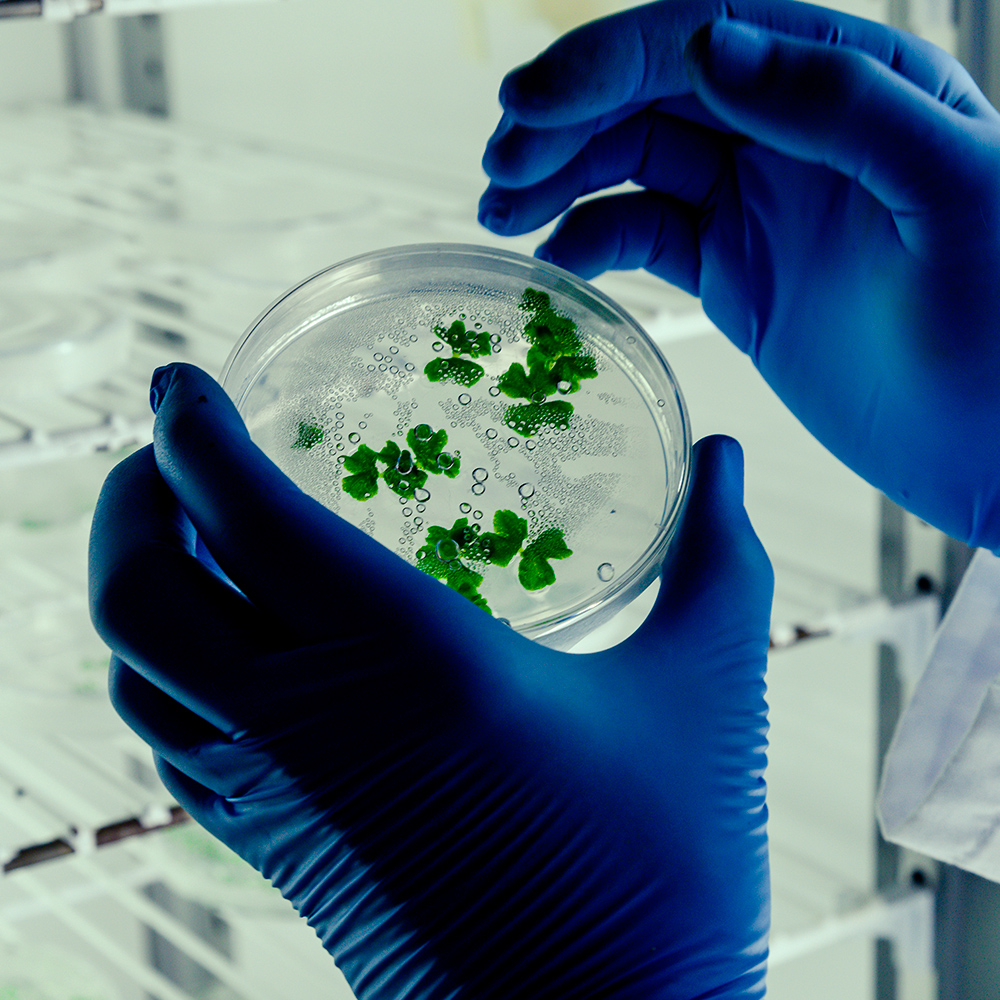
biologic2-green

Somos
Una empresa productora, distribuidora y comercializadora de microorganismos con potencial de biocontrol para ser utilizados con fines de manejo integrado tanto de plagas y enfermedades en la parte agrícola y pecuaria, buscando restaurar el equilibrio biológico natural en los diferentes sistemas de producción que se establecen en nuestros campos.

Lorem ipsum dolor sit amet, consectetur adipiscing elit, sed do eiusmod tempor incididunt ut labore et dolore magna aliqua. Ut enim ad minim veniam, quis nostrud exercitation ullamco laboris nisi ut aliquip ex ea commodo consequat.
Acerca de Nosotros

MISIÓN
Producir, distribuir y comercializar microorganismos con potencial de biocontrol de óptima calidad a nivel nacional e internacional, satisfaciendo las necesidades y expectativas de nuestros clientes tanto en el sector agrícola como pecuario en los diferentes sistemas de producción de nuestro país y vecinos, buscando un equilibrio con el medio ambiente.

VISIÓN
Consolidar y ampliar la participación en el mercado nacional e internacional de microorganismos con potencial de biocontrol de excelente calidad de la empresa SANOPLANT. Constituir alianzas estratégicas con otras empresas para producir y comercializar estos insumos.

POLÍTICA DE CALIDAD
Ofrecer Productos y Servicios de Calidad, teniendo como Filosofía Gerencial el Bienestar y Desarrollo de sus Colaboradores, haciéndolos partícipes de la Planificación de la Empresa, aplicando un Alto Nivel Tecnológico en sus Recursos Físicos y un Ambiente Estimulante de Trabajo, con Procesos de Mejoramiento Continuo en la Producción de Microorganismos con Potencial de Biocontrol con Enfoque Organico / Biologico Certificado.

¡Regístrate para recibir nuestro boletín informativo, enterarte de eventos y obtener descuentos!
